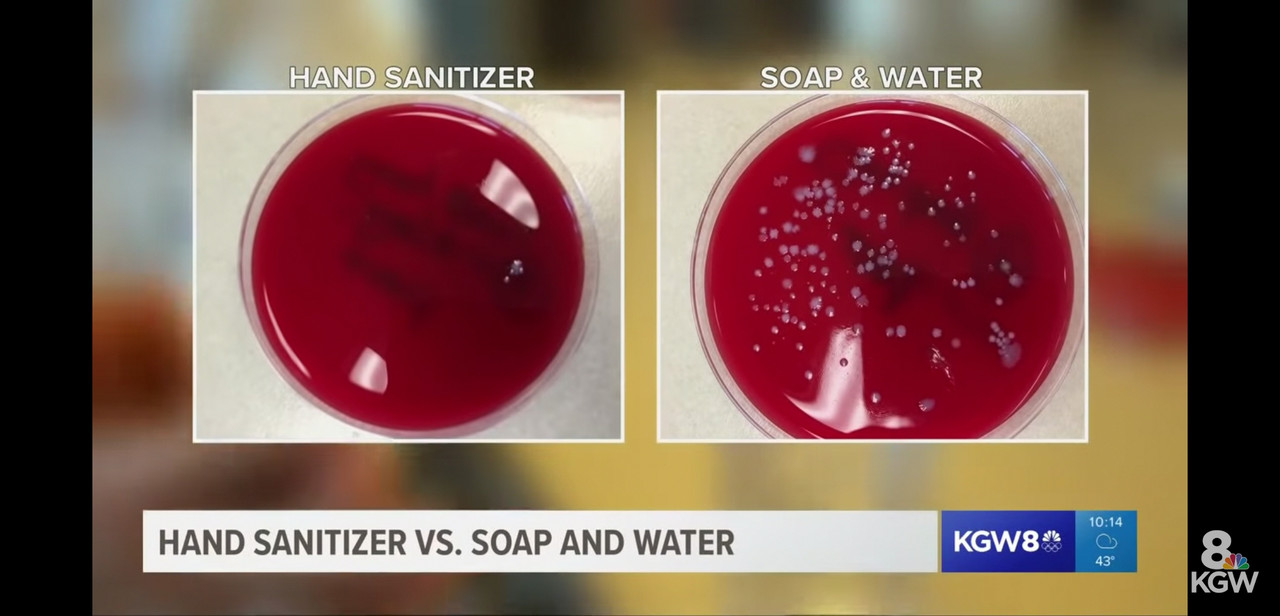

soal DBD ini juga lucu sihmpvlover wrote:Kenapa indo bergerak sangat lambat ttg corona ini dibanding negara lain ?
Karena selama ini negara anggap nyawa penduduk indo kan murah
Demam berdarah bunuh ribuan org per taun
TBC dr perokok dan asap motor bunuh puluhan ribu per taun
Tapi negara diem aja kan, produksi rokok dan motor digenjot terus
Negara negara laen udah ga ada demam berdarah, di indo mah ga berkurang
Kenapa ? Karena dua penyakit diatas biasanya menyerang rakyat miskin. Kalo menteri kena demam berdarah kan tinggal dirawat di rumahsakit mewah, cuti kerja dua minggu deh. Ribuan org mati? Salah sendiri siapa suruh ga jaga kebersihan, kata negara
Jadi negara kaget dgn corona ini ga siap. Walah, menteri kok bisa kena. Waduh, kok siapa aja bisa kena toh
Tapi karena negara gak pernah mau keluarin ratusan milyar buat demam berdarah, makanya negara pelit banget kalo soal kesehatan
Misi menkes kemaren yg ke daerah utk demam berdarah yg ada ratusan korban tewas ? Yang dibawa 75 biji raket nyamuk. Tujuh puluh lima. Anggaran ketat coy, tapi perjalanan dinas mah enggak
di Indo orang2 seneng banget mancing / nangkep ikan bahkan sampe ke got2 kecil, pada gak mikir ikan2 yg agak gede itu = predator c u k / jentik nyamuk
giliran kena DBD jerit2
sy pernah amati di sebuah perumahan di Ciikupa, ada 1 zona terdiri dr 5 cluster yg dikelilingi danau, tapi kalo malam gak ada nyamuk / amat sgt sedikit nyamuk di sana, karena di zona tsb dilarang keras mancing / nangkap ikan di danau nya........